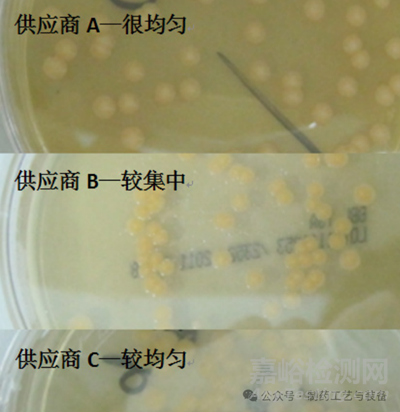

目的:通過對比 3 家不同供應(yīng)商的無菌預(yù)灌裝培養(yǎng)平皿實驗結(jié)果�,篩選出質(zhì)量較好的平皿培養(yǎng)基,同時探討其供應(yīng)商篩選�、進(jìn)廠檢查和使用方法,為無菌藥品生產(chǎn)企業(yè)進(jìn)行無菌預(yù)灌裝培養(yǎng)平皿的質(zhì)量控制工作提供參考�。
方法:分別對 3 家供應(yīng)商的無菌預(yù)灌裝培養(yǎng)平皿進(jìn)行 3 個批次的模擬使用,培養(yǎng)基無菌性�、內(nèi)層包裝袋無菌性、平皿密閉性和培養(yǎng)基適用性檢查�,篩選適合用于無菌生產(chǎn)區(qū)潔凈環(huán)境微生物監(jiān)測的平皿培養(yǎng)基。
結(jié)果:3家供應(yīng)商的模擬使用�、培養(yǎng)基無菌性和內(nèi)層包裝袋無菌性實驗結(jié)果沒有差異,供應(yīng)商 A 的平皿密閉性和培養(yǎng)基適用性實驗結(jié)果較另外兩家更好�。
結(jié)論:本實驗方法可用于篩選質(zhì)量較好的無菌預(yù)灌裝培養(yǎng)平皿。
微生物污染是藥品質(zhì)量評估的重要指標(biāo)[1]���,無菌藥品生產(chǎn)企業(yè)在生產(chǎn)車間核心區(qū)域監(jiān)測到微生物污染�����,說明藥品無菌生產(chǎn)過程存在安全隱患�����。為避免外源性污染進(jìn)入藥品生產(chǎn)車間[2]�����,2010版GMP規(guī)定:制藥企業(yè)需對潔凈環(huán)境進(jìn)行動態(tài)或靜態(tài)監(jiān)測���,使用沉降菌平皿���、空氣浮游菌平皿和表面接觸皿評估無菌生產(chǎn)的微生物狀況[3],制藥企業(yè)一般通過自配和購買無菌預(yù)灌裝培養(yǎng)平皿滿足其大量使用的需求�����。
自配的平皿培養(yǎng)基有一些值得探討的問題:①制備無菌平皿培養(yǎng)基需具備配皿�、包裝、抽真空�、伽馬射線終端滅菌等條件,工藝復(fù)雜,難以實現(xiàn)�����,如不進(jìn)行終端滅菌易造成假陽性結(jié)果[4]���;②經(jīng)100%的預(yù)培養(yǎng)后[5]�,需要對平皿培養(yǎng)基進(jìn)行無菌性檢查���,以防帶入外來的污染物到監(jiān)測區(qū)���;③使用容器裝放平皿�����,或直接將平皿傳入潔凈區(qū)使用���,也會污染生產(chǎn)區(qū)[6]�;④自配的平皿有效期短���,常小量多次配制�����,增加了批間差異和管理成本[7]���。
無菌預(yù)灌裝培養(yǎng)平皿采用雙層或三層抽真空包裝�,通過伽馬射線終端滅菌�,在使用時根據(jù)物料傳遞程序剝除外層包裝,避免外源性的微生物和顆粒通過物料傳遞過程污染無菌生產(chǎn)區(qū)[8]���,正逐漸受到無菌藥品生產(chǎn)企業(yè)的青睞�。
本文對無菌預(yù)灌裝培養(yǎng)平皿的供應(yīng)商篩選�����、進(jìn)廠檢查和日常使用方法進(jìn)行了探討�����,為無菌藥品生產(chǎn)企業(yè)進(jìn)行無菌預(yù)灌裝培養(yǎng)平皿的質(zhì)量控制工作提供參考���。
1�、實驗材料與方法
1.1培養(yǎng)基
無菌預(yù)灌裝培養(yǎng)平皿分別為胰酪大豆胨瓊脂培養(yǎng)基(Tryptose Soya Agar�,TSA)和沙氏葡萄糖瓊脂培養(yǎng)基(Sabouraud Dextrose Agar�,SDA)�����,規(guī)格為直徑90 cm�����,3層包裝�,伽馬輻照終端滅菌;樣品來自3家不同的供應(yīng)商�����,分別以供應(yīng)商A���、供應(yīng)商B、供應(yīng)商C表示���。
1.2主要儀器設(shè)備和耗材
BHC-1000ⅡA/B3型生物安全柜(蘇州安泰空氣技術(shù)有限公司)���;DENSIMT型細(xì)菌比濁儀(法國梅里埃診斷產(chǎn)品有限公司);GNP-9270型隔水式培養(yǎng)箱(上海精華宏實驗設(shè)備有限公司)�;直徑90 cm空平皿,6004型數(shù)字風(fēng)速計(日本加野麥克斯公司);無菌涂布棒�����,移液器���,G560E型電動混勻器(美國Scientific Industries公司)�。
1.3菌種
金黃色葡萄球菌[CMCC(B)26003]�,銅綠假單胞菌[CMCC(B)10104],生孢梭菌[CMCC(B)64941]�,枯草芽孢桿菌[CMCC(B)63501],白色念珠菌[CMCC(F)98001]���,黑曲霉[CMCC(F)98003]���,均購自中國食品藥品檢定研究院,試驗用菌種的傳代次數(shù)不得超過5代���。
1.4實驗方法
1.4.1 模擬使用
模擬日常使用過程�����,人員打開或關(guān)閉平皿動作應(yīng)流暢�����,將每家供應(yīng)商產(chǎn)品進(jìn)行3個不同批次的獨立試驗�����。平皿堆疊移動時應(yīng)穩(wěn)固�����。
1.4.2 培養(yǎng)基無菌性檢查
取2個TSA和SDA�,置30~35 ℃和20~25 ℃下培養(yǎng)72 h和5 d后,觀察結(jié)果���,將每個供應(yīng)商產(chǎn)品進(jìn)行3個不同批次的獨立平行試驗�。經(jīng)培養(yǎng)后���,2個平皿應(yīng)無菌生長�����。
1.4.3 密封內(nèi)包裝無菌性檢查
取2袋裝TSA和SDA,無菌操作打開第一層和第二層包裝�,用TSA接觸皿于第二層和第三層包裝表面取樣���,接觸時間應(yīng)不少于10 s,置30~35 ℃培養(yǎng)72 h后�����,觀察結(jié)果���,將每個供應(yīng)商產(chǎn)品進(jìn)行3個不同批次的獨立平行試驗�����。第二層和第三層包裝應(yīng)無菌生長�����。
1.4.4 平皿密閉性檢查
取2個TSA���,稱量其重量,于較高的側(cè)面風(fēng)速下倒置擺放72 h后���,再稱量其重量�,根據(jù)前后重量差計算失水率���,將每個供應(yīng)商產(chǎn)品進(jìn)行3個不同批次的獨立平行試驗���。氣流可吹至培養(yǎng)皿內(nèi)���,導(dǎo)致平皿污染、失水�,并在皿蓋上形成水珠或水霧,應(yīng)選擇失水率最少的產(chǎn)品���。
1.4.5 培養(yǎng)基適用性檢查
①樣品準(zhǔn)備:將待測無菌預(yù)灌裝培養(yǎng)平皿打開皿蓋���,在風(fēng)速為0.36~0.54 m·s-1的A級單向流下放置4 h后蓋上皿蓋;②菌液制備:取金黃色葡萄球菌�����、銅綠假單胞菌���、枯草芽孢桿菌�����、白色念珠菌的新鮮培養(yǎng)物���,用pH 7.0無菌氯化鈉-蛋白胨緩沖液制成不大于100 cfu/0.1 mL的菌懸液;取黑曲霉的新鮮培養(yǎng)物加入3~5 mL含0.05%聚山梨酯80的pH 7.0無菌氯化鈉-蛋白胨緩沖液�,將孢子洗脫,然后�����,采用適宜的方法吸出孢子懸液置無菌試管內(nèi)���,用含0.05%聚山梨酯80的pH 7.0無菌氯化鈉-蛋白胨緩沖液制成不大于100 cfu/0.1 mL的黑曲霉孢子懸液�����;③適用性檢查:接種0.1 mL不大于100 cfu的金黃色葡萄球菌���、銅綠假單胞菌、枯草芽孢桿菌�、白色念珠菌、黑曲霉孢子的菌液至TSA�����,均勻涂布���,在30~35 ℃培養(yǎng)72 h�,計數(shù);接種0.1 mL不大于100 cfu的白色念珠菌�����、黑曲霉菌孢子的菌液至SDA�����,均勻涂布�,在20~25 ℃培養(yǎng)5 d,計數(shù)���;每一試驗菌株平行制備2個平皿�,同時用國家對照培養(yǎng)基替代被檢培養(yǎng)基進(jìn)行上述試驗�,將每個供應(yīng)商產(chǎn)品進(jìn)行3個不同批次的獨立平行試驗。瓊脂表面不應(yīng)出現(xiàn)裂縫���、漣漪�、縮小等現(xiàn)象���,樣品培養(yǎng)基與對照培養(yǎng)基上菌落平均數(shù)的比值在0.5~2�����,且樣品培養(yǎng)基的菌落形態(tài)大小與對照培養(yǎng)基上的一致���,無明顯差異[9]。
2���、結(jié)果
2.1模擬使用
3家供應(yīng)商3個不同批次的TSA和SDA模擬日常使用過程均符合要求�。
2.2培養(yǎng)基無菌性檢查
3家供應(yīng)商3個不同批次的TSA和SDA經(jīng)培養(yǎng)后均無菌生長���。
2.3密封內(nèi)包裝無菌性檢查
3家供應(yīng)商3個不同批次的第二層和第三層包裝均無菌生長�����。
2.4平皿密閉性檢查
以風(fēng)速為1.44 m·s-1側(cè)吹平皿�����,測試結(jié)果見表1和圖1���。供應(yīng)商A平皿表面外觀正常,皿蓋沒有產(chǎn)生水珠,失水率最低�,與供應(yīng)商B和C差異明顯,能有效地減少培養(yǎng)過程中外界環(huán)境的影響�。
表1 平皿密閉性測試結(jié)果
圖1 平皿密閉性測試
2.5培養(yǎng)基適用性檢查
按《中國藥典》2015 年版四部“1105 非無菌產(chǎn)品微生物限度檢查:微生物計數(shù)法”規(guī)定[5]�,培養(yǎng)基適用性以回收率和菌落形態(tài)作判定標(biāo)準(zhǔn),瓊脂培養(yǎng)基在經(jīng)過 A 級單向流放置后�����,含水量對微生物的促生長起至關(guān)重要的作用�;普遍以瓊脂培養(yǎng)基是否出現(xiàn)裂縫、漣漪�、縮小等現(xiàn)象作為不合格標(biāo)準(zhǔn),但較難觀察與比較���。
本實驗采用菌落分布指標(biāo) [10]�,該指標(biāo)與瓊脂培養(yǎng)基的含水量相關(guān)�,當(dāng)含水量高的培養(yǎng)基在較小量的菌懸液操作情況下能涂開,于是經(jīng)培養(yǎng)后菌落在平板上的分布較均勻�;而含水量較少的培養(yǎng)基,當(dāng)加入較小量的菌懸液后���,培養(yǎng)基立刻將水分吸收�,使菌懸液不能均勻地涂布至平板中�����,于是經(jīng)培養(yǎng)后菌落在平板上的分布較集中,見圖 2�?��;诰涞姆植记闆r���,使用“很均勻 > 較均勻 > 較集中”表示菌落均勻程度。
圖2 菌落分布情況比對
圖3 大腸埃希菌菌落形態(tài)比對
本實驗使用 0.1 mL 菌懸液接種涂布 [11]�,測試結(jié)果見表 2 和表 3。供應(yīng)商 A 培養(yǎng)基質(zhì)量符合要求���;供應(yīng)商 B 培養(yǎng)基黑曲霉回收率在第一次測試中不符合規(guī)定(42.2%)�����,且大腸埃希菌的菌落形態(tài)和大小與國家標(biāo)準(zhǔn)培養(yǎng)基上的不一致�����,見圖 3���,瓊脂平皿含水量也低�;供應(yīng)商 C 培養(yǎng)基的菌落分布(含水量)不如供應(yīng)商 A���。
表2 TSA培養(yǎng)基適用性檢查結(jié)果
表3 SDA培養(yǎng)基適用性檢查結(jié)果
3、討論
3.1供應(yīng)商篩選
本實驗經(jīng)模擬使用�,培養(yǎng)基無菌性、密封內(nèi)包裝無菌性�、平皿密閉性和培養(yǎng)基適用性測試后,發(fā)現(xiàn)不同供應(yīng)商的無菌預(yù)灌裝培養(yǎng)平皿有差異�����,本研究最終選用供應(yīng)商A的產(chǎn)品�����。
有的供應(yīng)商為了減少平皿培養(yǎng)基在培養(yǎng)過程中的失水量���,皿蓋與皿底非常密合�����,這樣會造成平皿培養(yǎng)基打開或關(guān)閉時困難�����,建議在模擬使用測試符合要求的情況下選用密閉性能較高的平皿培養(yǎng)基�����。
3.2進(jìn)廠檢查
應(yīng)對每個生產(chǎn)批次的無菌預(yù)灌裝培養(yǎng)平皿進(jìn)行質(zhì)量控制[12]�����,包括核對供應(yīng)商質(zhì)檢證書[13](Certificate of Authenticity���,COA)、外觀檢查�、培養(yǎng)基無菌性檢查、密封內(nèi)包裝無菌性檢查和培養(yǎng)基適用性檢查�����。
圖4 含水珠的最內(nèi)層包裝
外觀檢查可包括:①冷凝水�,最內(nèi)層包裝袋應(yīng)不存在明顯的水滴和氣泡���,見圖4,平皿蓋及皿蓋邊緣不應(yīng)存在流動水滴�����,平皿培養(yǎng)基表面不應(yīng)存在流動水滴���;②培養(yǎng)基���,皿蓋不應(yīng)有流動水,培養(yǎng)基表面不應(yīng)有氣泡�����、流動水�、漣漪、開裂�����、雜物等現(xiàn)象�,見圖5。
圖5 外觀檢查缺陷
3.3日常使用
建議:①根據(jù)自身環(huán)境需求���,選取帶有中和劑成分的無菌預(yù)灌裝培養(yǎng)平皿 [14]�����;②操作人員在使用前應(yīng)目視檢查質(zhì)量�,包括外觀和菌落生長檢查;③要求供應(yīng)商在最內(nèi)層包裝內(nèi)附帶 1 個或 2 個透氣呼吸袋���,將取樣后的平皿培養(yǎng)基放入透氣呼吸袋內(nèi)密封�,然后轉(zhuǎn)移至質(zhì)量控制部培養(yǎng)�,培養(yǎng)結(jié)束后,打開包裝���,點計最終的菌落結(jié)果���;透氣呼吸袋能有效阻止外源性微生物污染 [15]�����,避免源于物料傳遞或培養(yǎng)過程的假陽性結(jié)果���。
參考文獻(xiàn)
[1] 鄭小玲�,王征南,王知堅���,等 . 藥品微生物檢測實驗室環(huán)境菌庫的建立 [J] . 中國現(xiàn)代應(yīng)用藥學(xué)�,2015���,32(7):847-850.
[2] 范一靈���,馮震,鐘瑋���,等 . 無菌藥品生產(chǎn)企業(yè)核心區(qū)微生物污染調(diào)查與分析 [J] . 中國藥事���,2014,28(6):586-590.
[3] 王秀梅 . 淺析新版 GMP 無菌藥品生產(chǎn)環(huán)境監(jiān)測 [J]. 山東化工�����,2013���,42(9):186-188.
[4] 蔣淑宏 . 微生物檢驗中培養(yǎng)基的質(zhì)量控制 [J]. 中國衛(wèi)生標(biāo)準(zhǔn)管理���,2015�����,(15):171-172.
[5] 中國藥典:四部 [S]. 2015:通則 9203���,通則 1105.
[6] 方芳,馬其勝�����,尹群�����,等 . 無菌工藝模擬試驗的研究 [J].中國醫(yī)藥工業(yè)雜志�����,2013�����,44(4):415-419.
[7] 劉茜�����,姜俊慧�,張慧慧,等 . 藥品檢驗用培養(yǎng)基配制及滅菌后貯存有效期的研究 [J]. 藥學(xué)研究���,2015�����,34(2):81-83.
[8] 余峰���,王旭,肖益熱�����,等 . 制藥廠房潔凈車間物流的防交叉污染設(shè)計實踐 [J]. 中外食品工業(yè)���,2014�����,(9):42-43.
[9] 景榮先�����,張國林 . 2015 年版《中國藥典》微生物限度檢查法潔凈環(huán)境及計數(shù)培養(yǎng)基修訂分析探討 [J]. 中國衛(wèi)生產(chǎn)業(yè)���,2015�,(5):184-185.
[10] 朱亞虹�,黃凱,曾環(huán)想 . 藥品微生物檢測的質(zhì)量保證[J] . 中國醫(yī)藥指南�����,2010�����,8(33):176-176.
[11] 馬緒榮�����,蘇德模 . 藥品微生物學(xué)檢驗手冊 [M] . 北京:科學(xué)出版社���,2000:86-86.
[12] 王綏家�,黃宏星 . 微生物實驗室培養(yǎng)基的質(zhì)量控制 [J].檢驗醫(yī)學(xué)與臨床���,2011�,8(20):2557-2558.
[13] 張喜 . 商品微生物培養(yǎng)基質(zhì)量狀況及其控制 [J]. 當(dāng)代醫(yī)學(xué)���,2009���,15(16):37-38.
[14] 潘友文,錢維清���,熊家娟 . 現(xiàn)代醫(yī)藥工業(yè)微生物實驗室質(zhì)量管理與驗證技術(shù) [M]. 北京:中國協(xié)和醫(yī)科大學(xué)出版社�����,2004:118-118.
[15] 國家食品藥品監(jiān)督管理局藥品認(rèn)證管理中心 . 藥品GMP 指南:無菌制劑 GMP 實施指南 [M]. 北京:中國醫(yī)藥科技出版社�,2011:40-40.
本文作者黃家樂���、王玥�、何睿�����、裘暢���、董鑄雄�,廣東天普生化醫(yī)藥股份有限公司,來源于中國藥事�,僅供交流學(xué)習(xí)。